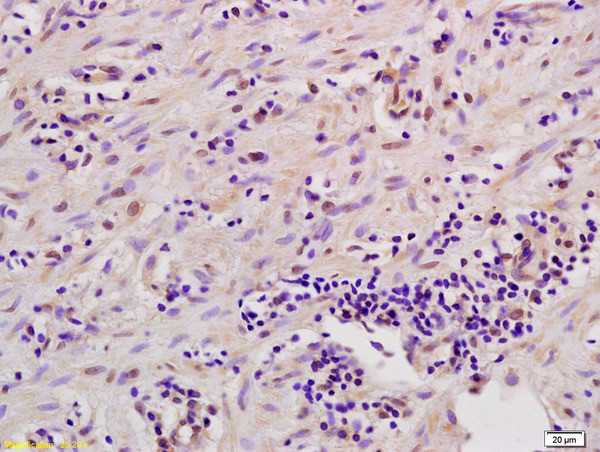
MSK1/2 Antibody in Immunohistochemistry (Paraffin) (IHC (P))

Search
Bioss
MSK1/2 Polyclonal Antibody
{{$productOrderCtrl.translations['antibody.pdp.commerceCard.promotion.promotions']}}
{{$productOrderCtrl.translations['antibody.pdp.commerceCard.promotion.viewpromo']}}
{{$productOrderCtrl.translations['antibody.pdp.commerceCard.promotion.promocode']}}: {{promo.promoCode}} {{promo.promoTitle}} {{promo.promoDescription}}. {{$productOrderCtrl.translations['antibody.pdp.commerceCard.promotion.learnmore']}}
产品信息
BS-2995R
种属反应
宿主/亚型
分类
类型
抗原
偶联物
形式
浓度
规格
纯化类型
保存液
内含物
保存条件
运输条件
靶标信息
MSK1 is a mitogen and stress activated protein kinase 1 which belongs to the AGC family of kinases and is related in structure to the ribosomal p70 S6 kinase subfamily. MSK1 can be activated by ERK1/2 and SAPK2/p38 MAP kinase. It is also known to be required for the phosphorylation of CREB, ATF1 H3 and HMG14 in response to mitogen and stress. Similar to RSK, MSK1 contains two kinase domains (N term and a C term). Once phosphorylated on Thr581 and Ser360 by ERK1/2 and SAPK2/p38, MSK1 autophosphorylate on at least 5 sites. Of these autophosphorylation sites Ser212 and Ser376 get phosphorylated by the C terminal kinase domain of MSK1 which is essential for the catalytic activity of the N terminal kinase domain. MSK2 plays an essential role in the control of RELA transcriptional activity in response to TNF. Phosphorylates 'Ser-10' of histone H3 in response to mitogenics, stress stimuli and EGF, which results in the transcriptional activation of several immediate early genes, including proto-oncogenes c-fos/FOS and c-jun/JUN. May also phosphorylate 'Ser-28' of histone H3. Mediates the mitogen- and stress-induced phosphorylation of high mobility group protein 1 (HMGN1/HMG14). In lipopolysaccharide-stimulated primary macrophages, acts downstream of the Toll-like receptor TLR4 to limit the production of pro-inflammatory cytokines. Functions probably by inducing transcription of the MAP kinase phosphatase DUSP1 and the anti-inflammatory cytokine interleukin 10 (IL10), via CREB1 and ATF1 transcription factors.
仅用于科研。不用于诊断过程。未经明确授权不得转售。
篇参考文献 (0)
生物信息学
蛋白别名: 90 kDa ribosomal protein S6 kinase 4; 90 kDa ribosomal protein S6 kinase 5; coiled-coil domain containing 88B; mitogen and stress-activated protein kinase 1; mitogen- and stress-activated protein kinase 2; mitogen- and stress-activated protein kinase-2; Nuclear mitogen- and stress-activated protein kinase 1; Nuclear mitogen- and stress-activated protein kinase 2; Ribosomal protein kinase B; Ribosomal protein S6 kinase alpha-4; Ribosomal protein S6 kinase alpha-5; ribosomal protein S6 kinase, 90kD, polypeptide 4; ribosomal protein S6 kinase, 90kDa, polypeptide 4; ribosomal protein S6 kinase, 90kDa, polypeptide 5; RLSK; RSK-like protein kinase; RSKB; RSKL; S6K-alpha-4; S6K-alpha-5; S6PKH2; unnamed protein product
基因别名: 1110069D02Rik; 3110005L17Rik; 6330404E13Rik; 90kDa; AI848992; AI854034; Ccdc88b; mMSK2; MSK1; MSK2; MSPK1; RLPK; RPS6KA4; RPS6KA5; RSK-B; S6K-alpha-4
UniProt ID: (Human) O75676, (Human) O75582, (Mouse) Q9Z2B9, (Mouse) Q8C050
Entrez Gene ID: (Human) 8986, (Human) 9252, (Mouse) 56613, (Rat) 361715, (Mouse) 73086, (Rat) 314384